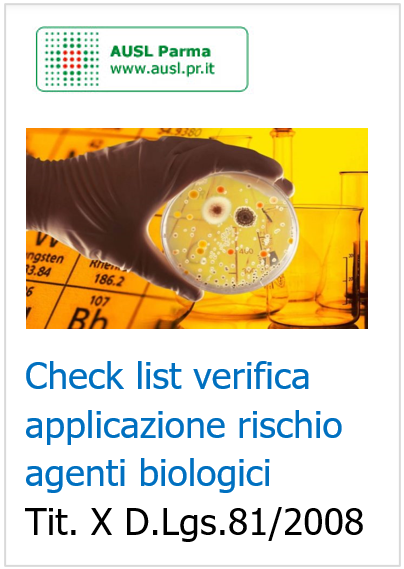
Check list verifica applicazione rischio biologico Titolo X D Lgs  81 2008

Check list verifica applicazione rischio biologico Titolo X D.Lgs. 81/2008
| ID 17638 | | Visite: 5339 | Documenti Sicurezza Enti | Permalink: https://www.certifico.com/id/17638 |
Check list per la verifica dell’applicazione del D.Lgs. 81/2008 titolo X esposizione ad agenti biologici
ID 176378 | AUSL PR 2012
Check list puntuale su quanto previsto dal D.Lgs. 81/2008 Titolo X Agenti biologici
...
segue in allegato
Collegati
Il monitoraggio microbiologico negli ambienti di lavoro
Il rischio biologico nei luoghi di lavoro - INAIL
Applicativo Valutazione del rischio biologico INAIL
Il rischio biologico negli ambulatori “Prime Cure” - INAIL 2015
Danno biologico: monitoraggio, criticità e prospettive - INAIL
Manuale informativo Il rischio biologico per i soccorritori non sanitari dell'emergenza
Rischio biologico Coronavirus | Titolo X D.Lgs. 81/08
Risk assessment for biological agents EU-OSHA
| Descrizione | Livello | Dimensione | Downloads | |
|---|---|---|---|---|
| Check list verifica applicazione rischio agenti biologici Titolo X D.Lgs. 81 2008.pdf AUSL PR 2012 |
135 kB | 251 |